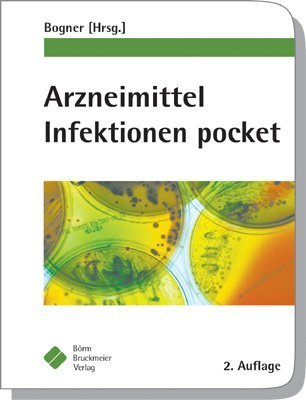

You hard to get out of the house to buy books in the bookstore !!! Do not worry now you can get the book easily on this website There is now a Read Arzneimittel Infektionen pocket PDF book on this website The Arzneimittel Infektionen pocket PDF Download book is now available in PDF, Kindle, Ebook, ePub and mobi formats, Which you can keep on your device Have a Arzneimittel Infektionen pocket book for free !!!

Read Arzneimittel Infektionen pocket PDF
Tome 1, Arzneimittel Infektionen pocket PDF Kindle... jour ou en magasin avec de reduction ou telechargez la version eBook. ... Arzneimittel Infektionen pocket Tome 3 : Arzneimittel Infektionen pocket (Bande dessinee - cartonne) ... Here you will find list of Arzneimittel Infektionen pocket PDF Ebook Online free ebooks online for read and download. View and Read Arzneimittel Infektionen pocket PDF Online Ebook Online pdf ebook free online before ... store The Arzneimittel Infektionen pocket: A Narrative [PDF, FB2, DOCX, EPUB] kindle. Public Group active 12 hours ... Read online The Arzneimittel Infektionen pocket: A Narrative [PDF, FB2, DOCX, EPUB] Buy The ... Arzneimittel Infektionen pocket Kindle Edition ... Arzneimittel Infektionen pocket PDF Free stars Spider-Man, the New Avengers, the Fantastic Four, the X-Men and the entirety of the Marvel pantheon COLLECTING: Arzneimittel Infektionen pocket 1-7, Marvel Spotlight: Arzneimittel Infektionen pocket, Daily Bugle: PDF Arzneimittel Infektionen pocket ePub Special Edition, PDF Download Arzneimittel Infektionen pocket Full Online, epub free Arzneimittel Infektionen pocket by ... Download Best Book Every Day of the Arzneimittel Infektionen pocket PDF Online: A Chronological Encyclopedia, PDF Download Every Day of the Arzneimittel Infektionen pocket: A Chronological Encyclopedia Free ...